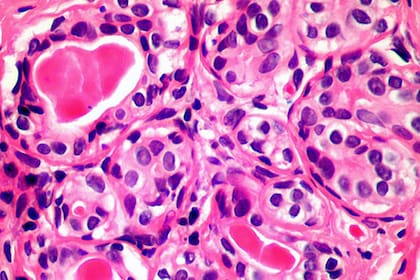
La nueva técnica podría matar una amplia gama de células cancerosas, incluidas las de mama y próstata.

1 minuto de lectura'
Una de cada tres personas que lean estas líneas desarrollará un cáncer a lo largo de su vida, pero la mayoría se curará. Las posibilidades de superar esta enfermedad dependen de cuándo se diagnostica: casi nueve de cada diez enfermos tendrán un buen pronóstico si su tumor se detecta en estadios iniciales, pero solo uno de cada cuatro lo tendrá si el diagnóstico llega en estadios avanzados. Por esto es crucial desarrollar nuevos métodos de diagnóstico temprano. Las técnicas de análisis genético masivo de los pacientes intentan alcanzar un objetivo alucinante, pero posible: detectar el cáncer antes incluso de que aparezca.
Un estudio publicado este martes suma un nuevo paso hacia ese futuro: un análisis de sangre que detecta cinco tipos de cáncer hasta cuatro años antes de que se realice el diagnóstico usando métodos convencionales, como colonoscopias o mamografías. El trabajo, publicado en Nature Communications, ha sido realizado por un equipo de investigadores chinos y estadounidenses y es aún una prueba preliminar, pero prometedora.
La técnica se centra en la epigenética, un ámbito de la biología molecular que estudia cambios químicos que están sobre el ADN y que modifican la función de los genes. Se suele decir que si el ADN es como un larguísimo piano con todas las teclas necesarias para mantenernos vivos y sanos, la epigenética son los dedos del pianista que determinan qué notas se tocan y cómo. Los cambios epigenéticos explican por qué el estilo de vida de un padre puede afectar a la salud de sus hijos, por ejemplo y, en general, explican cómo las cosas a las que estamos expuestos en nuestro día a día pueden afectar al funcionamiento de nuestro genoma, teóricamente inmutable.
Investigadores
Los investigadores han recurrido a un gran banco de datos conocido como Estudio Longitudinal de Taizhou —una ciudad china— en el que se recogió plasma de más de 100.000 voluntarios entre 2007 y 2014 y después se siguió su salud de por vida. Entre todos ellos, los investigadores se han centrado en el plasma de 605 personas entre las que 191 desarrollaron cáncer cuatro años después de la primera extracción de sangre.
Esta gran biblioteca de plasma les ha permitido a los investigadores comparar la fiabilidad de un test que analiza la metilación, un tipo de cambio epigenético en el ADN de células tumorales que circula por el torrente sanguíneo y que puede delatar la presencia de cáncer en fases iniciales. Los científicos han hecho un análisis muy detallado hasta aglutinar casi 500 tipos diferentes de metilación que componen un retrato robot del cáncer casi imposible de confundir con el de una célula sana, de forma que evita al máximo los falsos positivos.
El nuevo método de diagnóstico, conocido como Panseer, fue capaz de detectar signos de cáncer en el plasma de los pacientes que teóricamente estaban sanos, pero que fueron diagnosticados con tumores cuatro años después, con una fiabilidad en torno al 90%.
Cinco tipos de cáncer
Los científicos se han centrado en cinco tipos de tumor: esófago, estómago, pulmón, hígado y colon. Estos cinco tipos de tumores suponen más de dos millones de muertes anuales solo en China y EE UU, resaltan los autores, "y la detección temprana podría reducir enormemente esas defunciones", añaden. Solo existen métodos de diagnóstico temprano fiables para el cáncer de colon y para el cáncer de pulmón, pero en este caso solo funciona para un número limitado de pacientes. Los métodos de diagnóstico temprano podrían ahorrar decenas de miles de millones de euros en tratamientos a los sistemas sanitarios, comentan los investigadores.
Pero la posibilidad de detectar el cáncer de forma prematura es solo el principio. Los propios responsables del trabajo advierten de que su test se ha probado con muestras de plasma ya almacenadas y que ahora es necesario probarlo en un entorno real para comprobar si realmente puede anticiparse cuatro años a los sistemas de detección convencionales.
Kun Zhang, bioingeniero de la Universidad de California en San Diego y coautor del estudio, explica que los primeros tests para un tipo de tumor podrían estar desarrollados en unos tres años, mientras los que pueden detectar tipos múltiples podrían tardar unos dos años más. Antes habrá que realizar ensayos clínicos con pacientes para demostrar su efectividad. Zhang, al igual que muchos de los otros firmantes del estudio, está vinculado a la empresa biotecnológica estadounidense Singlera Genomics, que se encargará del desarrollo de estos análisis.
Este tipo de análisis de sangre se conocen como biopsias líquidas. Ya existen algunas para tipos concretos de cáncer, aunque por ahora son métodos que se usan después del diagnóstico, por ejemplo para personalizar el tratamiento de un paciente concreto. Los investigadores de este estudio destacan que lo más probable es que en todos o casi todos los casos analizados los pacientes ya tenían cáncer, aunque no se les diagnosticó hasta cuatro años después. La idea sería usar este análisis de sangre como una prueba destinada a la población general para detectar casos ocultos y aumentar la vigilancia o aplicar otros métodos para intentar saber en qué órgano puede haber un tumor y confirmarlo con otras técnicas. El tratamiento comenzaría antes y por tanto las posibilidades de curación aumentarían, argumentan.
Técnica en desarrollo
"Esta técnica está aún en un punto inicial de desarrollo", advierte Rodrigo Dienstmann, investigador principal del Grupo Oncology Data Science del VHIO de Barcelona. Este experto en genómica del cáncer dice que desde el punto de vista técnico se trata de una primera prueba de que este análisis concreto funciona. Pero lo más importante en su opinión es que demuestra que el análisis de metilación del ADN tumoral "demuestra de nuevo que podría ser un buen método de diagnóstico precoz del cáncer".
Los tumores surgen cuando una célula acumula un número determinado de mutaciones genéticas causales del cáncer. El problema es que esas mutaciones, que son erratas en el código genético de la célula, son muy heterogéneas y cada paciente puede tener unas específicas, con lo que es difícil desarrollar un método de cribado basado solo en mutaciones. En cambio, las metilaciones del ADN "son mucho más recurrentes y los podemos llegar a ver en el 95% de los casos de cáncer", resalta Dienstmann. El ADN tumoral que detectan estos análisis de sangre procede de células del tumor que han muerto o que han sido destruidas por el sistema inmune y sus restos pasan al torrente sanguíneo.
Un estudio realizado en 2018 demostró que esta técnica puede no solo detectar el cáncer de forma temprana sino también identificar el órgano de origen, algo fundamental en estos tests. "No tiene mucho sentido poder decirle a alguien que tiene cáncer o que lo tendrá si no le dices dónde y cuándo pasará", resume el investigador.
Este nuevo test debe probarse ahora con pacientes actuales y comparar su efectividad con los métodos convencionales, como las colonoscopias o las mamografías y demostrar que mejora la supervivencia de los pacientes. "Dos aspectos importantes para la implantación de los métodos de cribado son la ratio coste-efectividad y la reducción de la mortalidad con la detección precoz", explica Teresa Alonso, secretaria científica de la Sociedad Española de Oncología Médica (SEOM). "Este estudio demuestra la capacidad de la técnica para la detección de estos cinco tipos tumorales cuatro años antes del diagnóstico con técnicas convencionales, pero una de las grandes limitaciones del estudio es que les faltaría determinar el impacto en supervivencia de una forma coste-efectiva de este método. A día de hoy estos estudios son costosos tanto a nivel económico como de interpretación, siendo difícil su aplicación generalizada en la población. Sin embargo, gracias a los avances tecnológicos, estas técnicas cada vez son más baratas y aplicables", añade.
© EL PAÍS, S.L.






